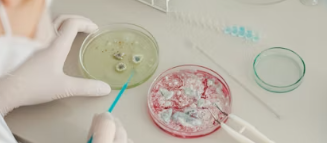

07
Apr
2026
Unexpected Thyroid Function Tests: Identifying Interference and Testing Errors
20:00 - 21:00
Virtual/Online
06
Apr
2026
Bridging the Gap – Redefining the Lab’s Role in Cervical Cancer Screening.
20:00 - 21:00
Virtual/Online
04
Apr
2026
From Manual to Machine – Best Practices in Automated Microbiology Lab
20:00 - 21:00
Virtaul/Online
03
Apr
2026
False Lows, Real Clues – Recognizing Anticoagulant-Induced Pseudothrombocytopenia
20:00 - 21:00
Virtual/Online
05
Apr
2026
02
Apr
2026
The Data is Already in your Lab – From Routine Culture and AST Results to AMR Intelligence
20:00 - 21:00
Virtual/Online
- Previous
- 1
- 2
- 3
- 4
- 5
- 6
- 7
- 8
- 9
- 10
- 11
- 12
- 13
- 14
- 15
- 16
- 17
- 18
- 19
- 20
- 21
- 22
- 23
- 24
- 25
- 26
- 27
- 28
- 29
- 30
- 31
- 32
- 33
- Next